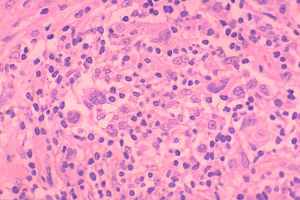
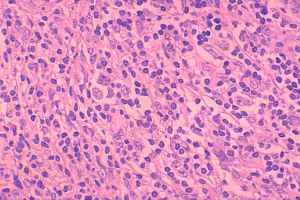

Thyroid cancers - case 1422 |
|
Clinical presentation: A 32-year-old woman was referred for an evaluation of an enlarged cervical lymph node.
Palpation: There were multiple, not freely moveable lymph nodes in both sides of the neck.
Functional state: euthyroidism.
Ultrasonography. Besides the enlarged lymph nodes, US revealed a hypoechogenic lesion in the left lobe of the thyroid.
Cytology from the lymph node and the thyroid yielded similar report, suspicion of Hodgkin's disease
Histopathology revealed Hodgkin's disease of mixed cellular type.
Histological images are courtesy of Dr. Zsolt Orosz, National Institute of Oncology, Budapest, Hungary.